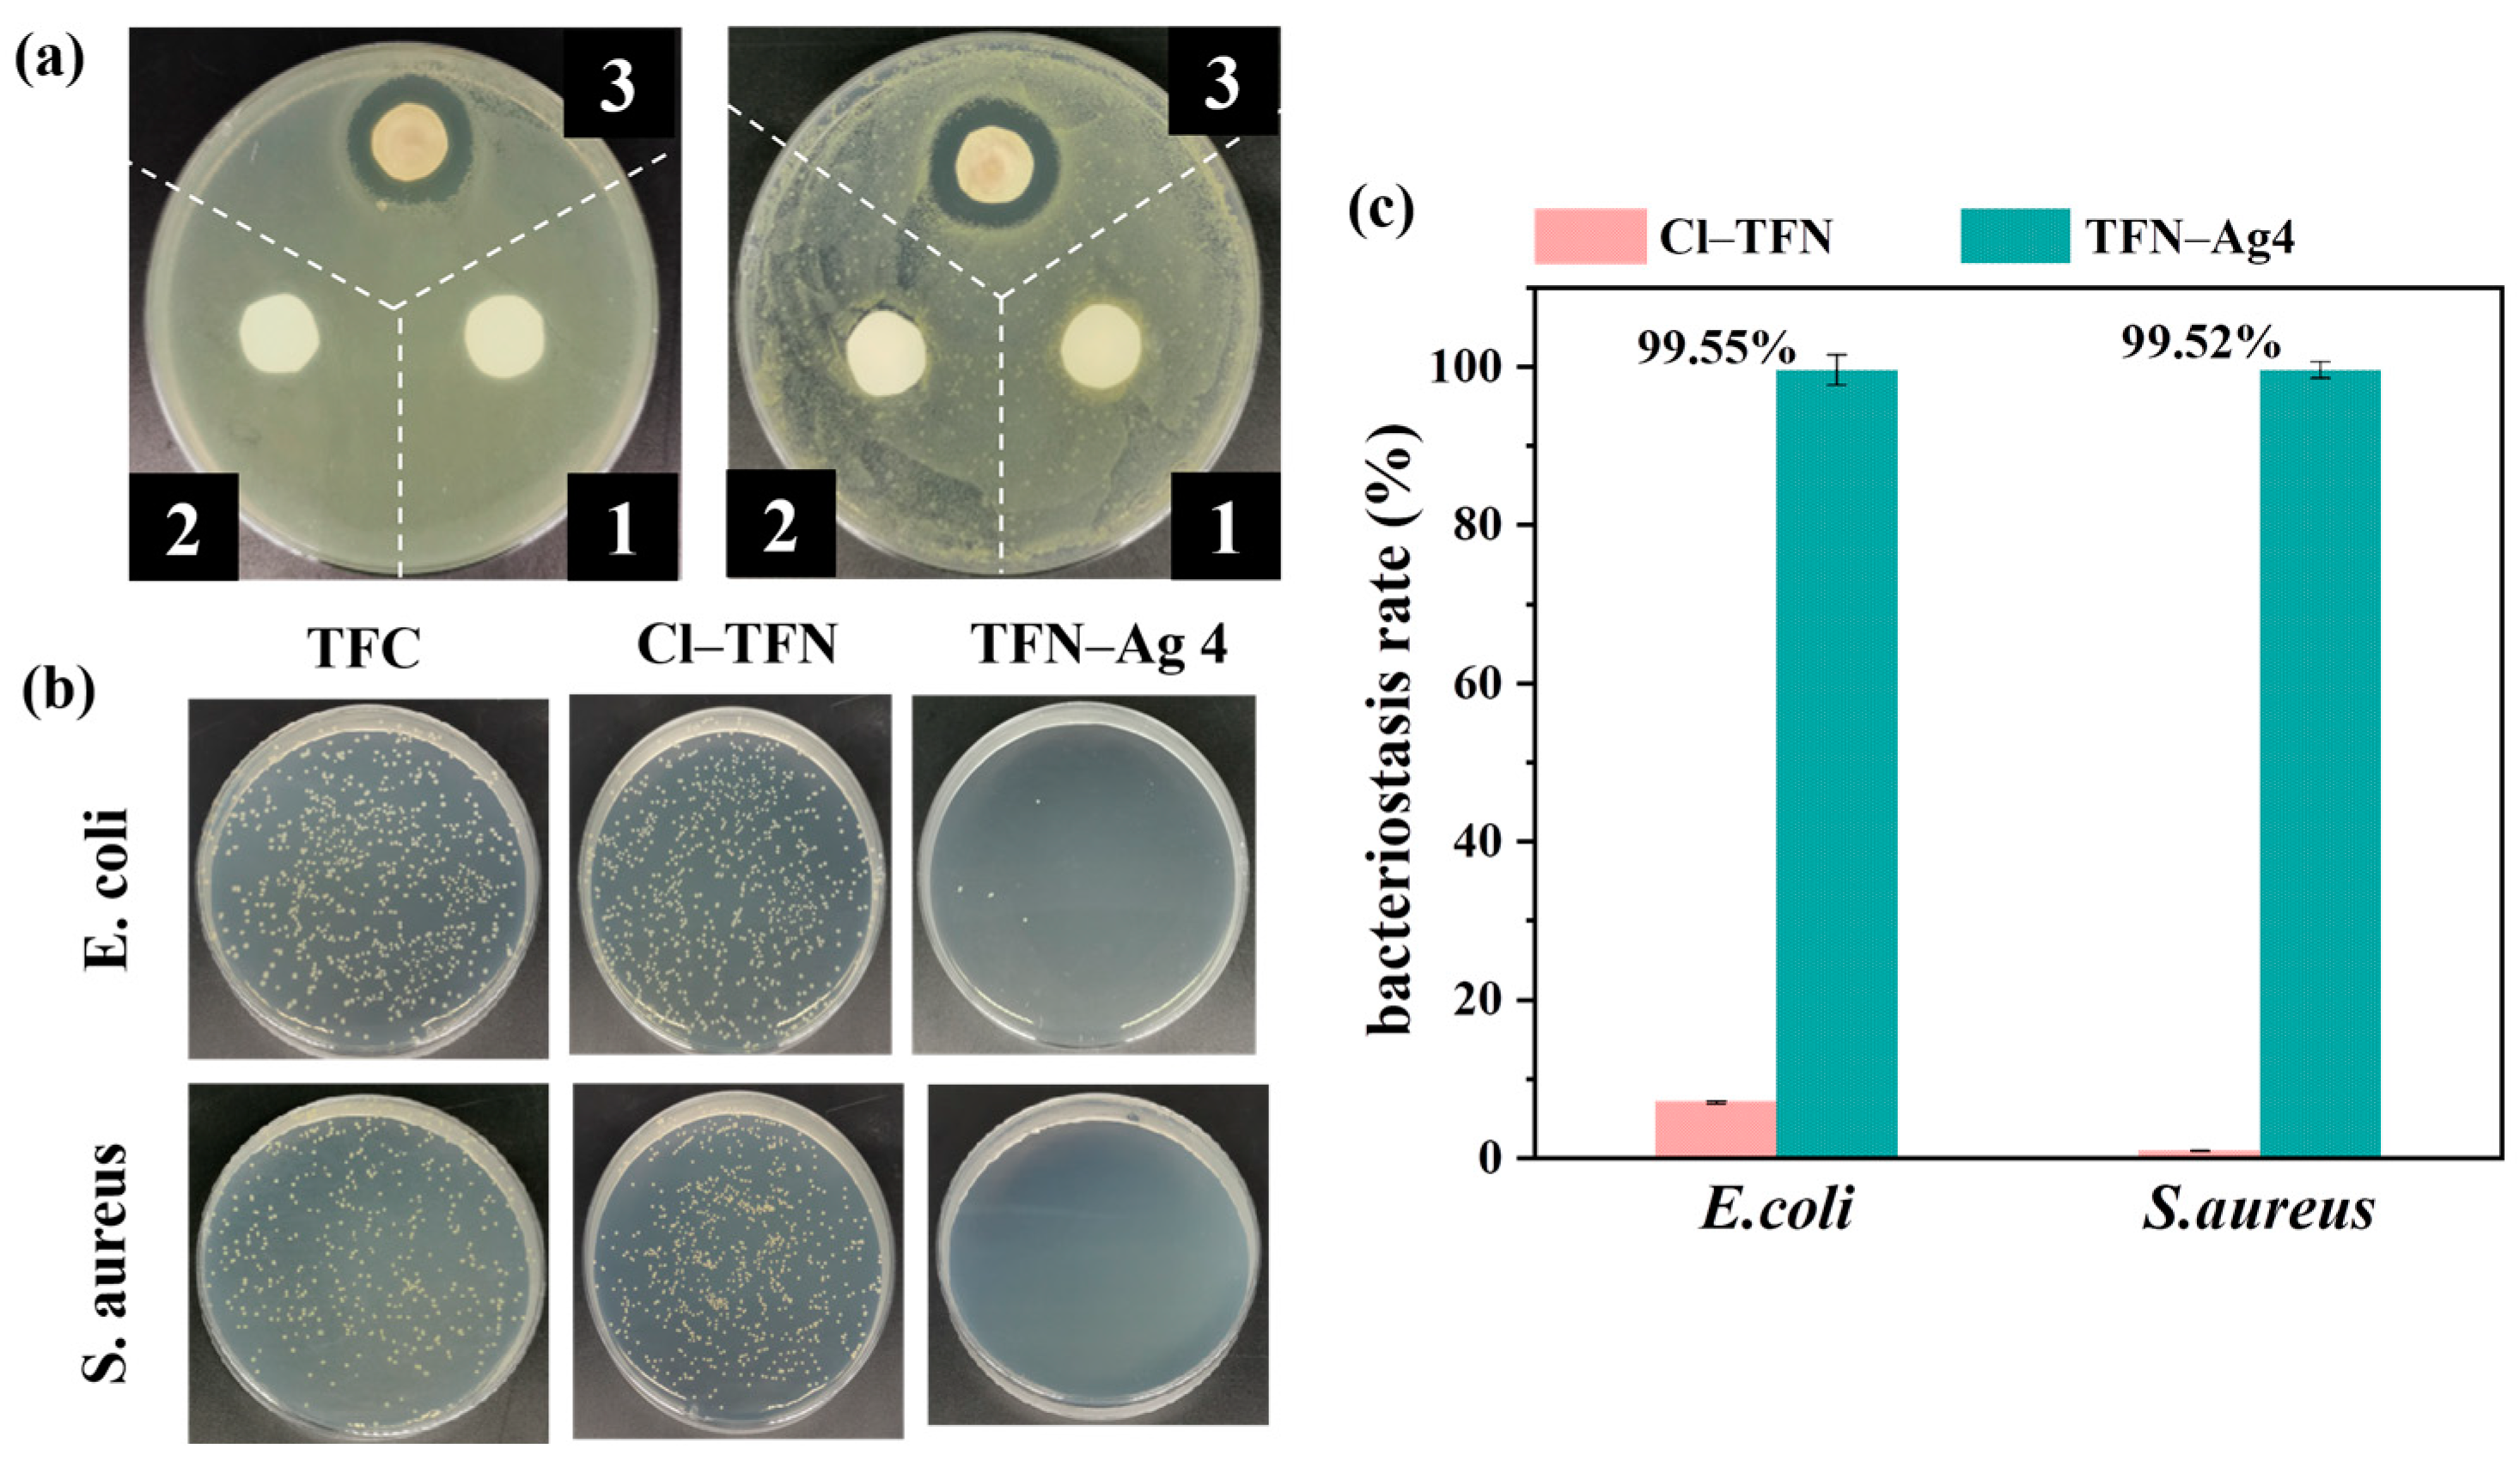
Membranes 13 00693 g010 Membranes 13 00693 g010

In Situ Formation of Silver Nanoparticles Induced by Cl-Doped Carbon Quantum Dots for Enhanced Separation and Antibacterial Performance of Nanofiltration Membrane
Abstract
1. Introduction
2. Experiment
2.1. Materials
2.2. Preparation of TFN-Ag Membranes
2.3. Characterizations
2.4. Separation Performances of TFN-Ag Membranes
2.5. Characterizations of Membrane Antibacterial Performance
2.6. Silver Release Experiments
3. Results and Discussion
3.1. The In Situ Formation of Ag NPs Induced by Cl-CQDs
3.2. Preparation of TFN-Ag Membranes via In Situ Formation Induced by Cl-CQDs
3.3. Separation Performance of Membranes
3.4. Antibacterial Performance of TFN-Ag Membrane
4. Conclusions
Author Contributions
Funding
Institutional Review Board Statement
Data Availability Statement
Conflicts of Interest
Abbreviations
| Name | Abbreviation |
| nanofiltration | NF |
| polyamide | PA |
| thin film composite | TFC |
| thin film nanocomposite | TFN |
| silver nanoparticles | Ag NPs |
| silver nitrate | AgNO3 |
| chloride-doped carbon quantum dots | Cl-CQDs |
| carbon quantum dots | CQDs |
| Escherichia coli | E. coli |
| Staphylococcus aureus | S. aureus |
| piperazine | PIP |
| trimesoyl chloride | TMC |
| sodium chloride | NaCl |
| sodium sulfate | Na2SO4 |
| magnesium sulfate | MgSO4 |
| ultraviolet–visible spectrometer | UV–vis spectrometer |
| scanning electron microscopy | SEM |
| energy dispersive X-ray spectra | EDX spectra |
| attenuated total reflectance Fourier transform infrared spectroscopy | ATR-FTIR |
| X-ray photoelectron spectroscopy | XPS |
| Luria–Bertani broth | LB broth |
| colony forming units per mL | CFU mL−1 |
References
- Labhasetwar, P.K.; Yadav, A. Membrane Based Point-of-Use Drinking Water Treatment Systems; IWA Publishing: London, UK, 2023. [Google Scholar]
- Zhang, W.; Li, N.; Zhang, X. Surface-engineered sulfonation of ion-selective nanofiltration membrane with robust scaling resistance for seawater desalination. J. Membr. Sci. 2022, 644, 120191. [Google Scholar] [CrossRef]
- Abdel Fatah, M.A. Nanofiltration systems and applications in wastewater treatment: Review article. Ain Shams Eng. 2018, 9, 3077–3092. [Google Scholar] [CrossRef]
- Li, P.F.; Lan, H.L.; Chen, K.; Ma, X.P.; Wei, B.X.; Wang, M.; Li, P.; Hou, Y.F.; Niu, Q.J. Novel high-flux positively charged aliphatic polyamide nanofiltration membrane for selective removal of heavy metals. Sep. Purif. Technol. 2022, 280, 11949. [Google Scholar] [CrossRef]
- Liu, J.X.; Cao, P.; Yu, X.R.; Li, T.; Sun, W.; Zhao, Y.X.; Yu, H.J.; Wang, Z.H.; Zeng, J.L.; Dong, B.Z.; et al. A coupled molybdenum disulfide-copper modification of NF membrane for enhanced anti-bacterial performance. Desalination 2023, 546, 116190. [Google Scholar] [CrossRef]
- Gohil, J.M.; Suresh, A.K. Chlorine attack on reverse osmosis membranes: Mechanisms and mitigation strategies. J. Membr. Sci. 2017, 541, 108–126. [Google Scholar] [CrossRef]
- Lau, W.J.; Ismail, A.F.; Misdan, N.; Kassim, M.A. A recent progress in thin film composite membrane: A review. Desalination 2012, 287, 190–199. [Google Scholar] [CrossRef]
- Nasir, A.M.; Adam, M.R.; Mohamad Kamal, S.A.; Jaafar, J.; Othman, M.H.D.; Ismail, A.F.; Aziz, F.; Yusof, N.; Bilad, M.R.; Mohamud, R.; et al. A review of the potential of conventional and advanced membrane technology in the removal of pathogens from wastewater. Sep. Purif. Technol. 2022, 286, 120454. [Google Scholar] [CrossRef]
- Liu, C.H.; Wang, Z.Y.; He, Q.; Jackson, J.; Faria, A.F.; Zhang, W.J.; Song, D.; Ma, J.; Sun, Z.Q. Facile preparation of anti-biofouling reverse osmosis membrane embedded with polydopamine-nano copper functionality: Performance and mechanism. J. Membr. Sci. 2022, 658, 120721. [Google Scholar] [CrossRef]
- Choi, W.; Lee, C.; Lee, D.; Won, Y.J.; Lee, G.W.; Shin, M.G.; Chun, B.; Kim, T.S.; Park, H.D.; Jung, H.W.; et al. Sharkskin-mimetic desalination membranes with ultralow biofouling. Mater. Chem. 2018, 6, 23034–23045. [Google Scholar] [CrossRef]
- Xiong, S.; Xu, S.; Phommachanh, A.; Yi, M.; Wang, Y. Versatile surface modification of TFC membrane by layer-by-layer assembly of phytic acid-metal complexes for comprehensively enhanced FO performance. Environ. Sci. Technol. 2019, 53, 3331–3341. [Google Scholar] [CrossRef]
- Wang, D.; Li, S.Y.; Li, F.L.; Li, J.M.; Li, N.; Wang, Z.N. Thin film nanocomposite membrane with triple-layer structure for enhanced water flux and antibacterial capacity. Sci. Total Environ. 2021, 770, 145370. [Google Scholar] [CrossRef] [PubMed]
- Lai, G.S.; Lau, W.J.; Goh, P.S.; Ismail, A.F.; Tan, Y.H.; Chong, C.Y.; Krause-Rehberg, R.; Awad, S. Tailor-made thin film nanocomposite membrane incorporated with graphene oxide using novel interfacial polymerization technique for enhanced water separation. Chem. Eng. J. 2018, 344, 524–534. [Google Scholar] [CrossRef]
- Zhao, D.L.; Yeung, W.S.; Zhao, Q.; Chung, T.S. Thin-film nanocomposite membranes incorporated with UiO-66-NH2 nanoparticles for brackish water and seawater desalination. J. Membr. Sci. 2020, 604, 118039. [Google Scholar] [CrossRef]
- Liu, C.; Faria, A.F.; Ma, J.; Elimelech, M. Mitigation of biofilm development on thin-film composite membranes functionalized with zwitterionic polymers and silver nanoparticles. Environ. Sci. Technol. 2017, 51, 182–191. [Google Scholar] [CrossRef] [PubMed]
- Liu, Z.; Hu, Y. Sustainable antibiofouling properties of thin film composite forward osmosis membrane with rechargeable silver nanoparticles loading. ACS Appl. Mater. Interfaces 2016, 8, 21666–21673. [Google Scholar] [CrossRef]
- Suresh, D.; Goh, P.S.; Ismail, A.F.; Mansur, S.B.; Wong, K.C.; Asraf, M.H.; Malek, N.; Wong, T.W. Complexation of tannic acid/silver nanoparticles on polyamide thin film composite reverse osmosis membrane for enhanced chlorine resistance and anti-biofouling properties. Desalination 2022, 543, 116107. [Google Scholar] [CrossRef]
- Saleem, H.; Zaidi, S.J. Nanoparticles in reverse osmosis membranes for desalination: A state of the art review. Desalination 2020, 475, 114171. [Google Scholar] [CrossRef]
- Liu, C.H.; He, Q.; Song, D.; Jackson, J.; Faria, A.F.; Jiang, X.H.; Li, X.Y.; Ma, J.; Sun, Z.Q. Electroless deposition of copper nanoparticles integrates polydopamine coating on reverse osmosis membranes for efficient biofouling mitigation. Water Res. 2022, 217, 118375. [Google Scholar] [CrossRef]
- Kim, S.J.; Lee, P.S.; Bano, S.; Park, Y.I.; Nam, S.E.; Lee, K.H. Effective incorporation of TiO2 nanoparticles into polyamide thin-film composite Membranes. Appl. Polym. Sci. 2016, 133, 43383. [Google Scholar] [CrossRef]
- Geng, C.B.; Zhao, F.B.; Wang, Q.; Zheng, S.; Liu, Y.; Niu, H.Y.; Zhang, J.M.; Dong, H.X. Anti-biofouling property and anti-leaching investigation of modifier for PVDF ultrafiltration. membrane by incorporating antibacterial graphene oxide derivatives. J. Environ. Chem. Eng. 2022, 10, 108558. [Google Scholar] [CrossRef]
- Geng, C.B.; Zhao, F.B.; Niu, H.Y.; Zhang, J.M.; Dong, H.X.; Li, Z.G.; Chen, H.X. Enhancing the permeability, anti-biofouling performance and long-term stability of TFC nanofiltration membrane by imidazole-modified carboxylated graphene oxide/polyethersulfone substrate. J. Membr. Sci. 2022, 664, 121099. [Google Scholar] [CrossRef]
- Chaubey, S.; Mehra, S.; Yadav, A.; Kumar, A.; Shahi, V.K. Investigation of antifouling and antibacterial properties of curcumin-enriched surfactant nanoparticles modified polysulfone nanocomposite membranes. Mater. Today Chem. 2022, 26, 101130. [Google Scholar] [CrossRef]
- Andrade, P.F.; Faria, A.F.; Oliveira, S.R.; Arruda, M.A.Z.; Gonçalves, M.C. Improved antibacterial activity of nanofiltration polysulfone membranes modified with silver nanoparticles. Water Res. 2015, 81, 333–342. [Google Scholar] [CrossRef]
- Zhai, Z.; Zhao, N.; Dong, W.; Li, P.; Sun, H.; Niu, Q.J. In situ assembly of a zeolite imidazolate framework hybrid thin-film nanocomposite membrane with enhanced desalination performance induced by noria-polyethyleneimine codeposition. ACS Appl. Mater. Interfaces 2019, 11, 12871–12879. [Google Scholar] [CrossRef]
- Lau, W.J.; Gray, S.; Matsuura, T.; Emadzadeh, D.; Chen, J.P.; Ismail, A.F. A review on polyamide thin film nanocomposite (TFN) membranes: History, applications, challenges and approaches. Water Res. 2015, 80, 306–324. [Google Scholar] [CrossRef] [PubMed]
- Zhu, J.; Qin, L.; Uliana, A.; Hou, J.; Wang, J.; Zhang, Y.; Li, X.; Yuan, S.; Li, J.; Tian, M.; et al. Elevated performance of thin film nanocomposite membranes enabled by modified hydrophilic MOFs for nanofiltration. ACS Appl. Mater. Interfaces 2017, 9, 1975–1986. [Google Scholar] [CrossRef]
- Zhao, D.L.; Jin, H.Y.; Zhao, Q.P.; Xu, Y.C.; Shen, L.G.; Lin, H.J.; Chung, T.S. Smart integration of MOFs and CQDs to fabricate defect-free and self-cleaning TFN membranes for dye removal. J. Membr. Sci. 2023, 679, 121706. [Google Scholar] [CrossRef]
- Kim, A.; Moon, S.J.; Kim, J.H.; Patel, R. Review on thin-film nanocomposite membranes with various quantum dots for water treatments. J. Ind. Eng. Chem. 2023, 118, 19–32. [Google Scholar] [CrossRef]
- Shao, D.D.; Yang, W.J.; Xiao, H.F.; Wang, Z.Y.; Zhou, C.; Cao, X.L.; Sun, S.P. Self-cleaning nanofiltration membranes by coordinated regulation of carbon quantum dots and polydopamine. ACS Appl. Mater. Interfaces 2020, 12, 580–590. [Google Scholar] [CrossRef]
- Fathizadeh, M.; Tien, H.N.; Khivantsev, K.; Song, Z.N.; Zhou, F.L.; Yu, M. Polyamide/nitrogen-doped graphene oxide quantum dots (N-GOQD) thin film nanocomposite reverse osmosis membranes for high flux desalination. Desalination 2019, 451, 125–132. [Google Scholar] [CrossRef]
- Lin, Y.Q.; Shen, Q.; Kawabata, Y.; Segawa, J.; Cao, X.Z.; Guan, K.C.; Istirokhatun, T.; Yoshioka, T.; Mastuyama, H. Graphene quantum dots (GQDs)-assembled membranes with intrinsic functionalized nanochannels for high-performance nanofiltration. Chem. Eng. J. 2021, 420, 1385–8947. [Google Scholar] [CrossRef]
- Murali, G.; Modigunta, J.K.R.; Park, S.; Lee, S.; Lee, H. Enhancing light absorption and prolonging charge separation in carbon quantum dots via Cl-doping for visible-light-driven photocharge-transfer reactions. ACS Appl. Mater. Interfaces 2021, 13, 34648–34657. [Google Scholar] [CrossRef]
- Choi, H.; Ko, S.J.; Choi, Y.; Joo, P.; Kim, T.; Lee, B.R.; Jung, J.W.; Choi, H.J.; Cha, M.; Jeong, J.R.; et al. Versatile surface plasmon resonance of carbon-dot-supported silver nanoparticles in polymer optoelectronic devices. Nat. Photonics 2013, 7, 732–738. [Google Scholar] [CrossRef]
- Liu, S.S.; Low, Z.X.M.; Hegab, H.; Xie, Z.L.; Ou, R.W.; Yang, G.P.; Simon, G.; Zhang, X.W.; Zhang, L.; Wang, H.T. Enhancement of desalination performance of thin-film nanocomposite membrane by cellulose nanofibers. J. Membr. Sci. 2019, 592, 117363–117386. [Google Scholar] [CrossRef]
- Celebioglu, A.; Topuz, F.; Yildiz, Z.I.; Uyar, T. One-step green synthesis of antibacterial silver nanoparticles embedded in electrospun cyclodextrin nanofibers. Carbohydr. Polym. 2019, 207, 471–479. [Google Scholar] [CrossRef] [PubMed]
- Wen, P.H.; Wang, Y.D.; Wang, N.; Zhang, S.W.; Peng, B.; Deng, Z.W. Preparation and characterization of melamine-formaldehyde/Ag composite microspheres with surface enhanced Raman scattering and antibacterial activities. J. Colloid Interface Sci. 2018, 531, 544–554. [Google Scholar] [CrossRef] [PubMed]
- Fang, W.X.; Ma, S.H.; Dong, H.; Jin, X.W.; Zou, Y.C.; Xu, K.X.; Zhang, L.; Luo, Y.H. Squarelike AgCl nanoparticles grown using NiCl2(Pyz)2-based metal-organic framework nanosheet templates for antibacterial applications. ACS Appl. Nano Mater. 2012, 4, 5541–5547. [Google Scholar] [CrossRef]
- Jin, H.Y.; Rivers, F.; Yin, H.D.; Lai, T.M.; Cay-Durgun, P.; Khosravi, A.; Lind, M.L.; Yu, P. Synthesis of AgCl mineralized thin film composite polyamide membranes to enhance performance and antifouling properties in forward osmosis. Ind. Eng. Chem. Res. 2017, 56, 1064–1073. [Google Scholar] [CrossRef]
- You, X.D.; Ma, T.Y.; Su, Y.L.; Wu, H.; Wu, M.Y.; Cai, H.W.; Sun, G.M.; Jiang, Z.Y. Enhancing the permeation flux and antifouling performance of polyamide nanofiltration membrane by incorporation of PEG-POSS nanoparticles. J. Membr. Sci. 2017, 540, 454–463. [Google Scholar] [CrossRef]
- Zhu, J.Y.; Hou, J.W.; Yuan, S.S.; Zhao, Y.; Li, Y.; Zhang, R.J.; Tian, M.M.; Li, J.; Wang, J.; Bruggen, B.V. MOF-positioned polyamide membrane with a fishnet-like structure for elevated nanofiltration performance. J. Mater. Chem. A 2019, 7, 16313–16322. [Google Scholar] [CrossRef]
- Karami, P.; Aktij, S.A.; Khorshidi, B.; Firouzjaei, M.D.; Asad, A.; Elliott, M.; Rahimpour, A.; Soares, J.B.P.; Sadrzadeh, M. Nanodiamond-decorated thin film composite membranes with antifouling and antibacterial properties. Desalination 2022, 522, 115436. [Google Scholar] [CrossRef]
- Yang, Z.; Takagi, R.; Zhang, X.Y.; Yasui, T.; Zhang, L.; Matsuyama, H. Engineering a dual-functional sulfonated polyelectrolyte-silver nanoparticle complex on a polyamide reverse osmosis membrane for robust biofouling mitigation. J. Membr. Sci. 2021, 618, 118757. [Google Scholar] [CrossRef]
- Ahmad, N.A.; Goh, P.S.; Wong, K.C.; Mamah, S.C.; Ismail, A.F.; Zulhairun, A.K. Accelerated spraying-assisted layer by layer assembly of polyethyleneimine/titania nanosheet on thin film composite membrane for reverse osmosis desalination. Desalination 2022, 529, 115645. [Google Scholar] [CrossRef]
- Yin, J.; Yang, Y.; Hu, Z.; Deng, B. Attachment of silver nanoparticles (Ag NPs) onto thin-film composite (TFC) membranes through covalent bonding to reduce membrane biofouling. J. Membr. Sci. 2013, 441, 73–82. [Google Scholar] [CrossRef]
- Li, C.; Zhang, J.; Han, J.; Yao, B. A numerical solution to the effects of surface roughness on water-coal contact angle. Sci. Rep. 2021, 11, 459. [Google Scholar] [CrossRef] [PubMed]
- Boo, C.; Wang, Y.; Zucker, I.; Choo, Y.; Osuji, C.O.; Elimelech, M. High performance nanofiltration membrane for effective removal of perfluoroalkyl substances at high water recovery. Environ. Sci. Technol. 2018, 52, 7279–7288. [Google Scholar] [CrossRef]
- Zhang, H.Z.; Xu, Z.L.; Shen, Q. High-performance nanofiltration membrane intercalated by FeOOH nanorods for water nanofiltration. Desalination 2021, 498, 114802. [Google Scholar] [CrossRef]
- Park, S.H.; Kim, S.H.; Park, S.J.; Ryoo, S.; Woo, K.; Lee, J.S.; Kim, T.S.; Park, H.D.; Park, H.; Park, Y.I.; et al. Direct incorporation of silver nanoparticles onto thin-film composite membranes via arc plasma deposition for enhanced antibacterial and permeation performance. J. Mater. Chem. A 2016, 513, 226–235. [Google Scholar] [CrossRef]
- Zhu, J.; Hou, J.; Zhang, Y.; Tian, M.; He, T.; Liu, J.; Chen, V. Polymeric antimicrobial membranes enabled by nanomaterials for water treatment. J. Membr. Sci. 2018, 550, 173–197. [Google Scholar] [CrossRef]
- Xu, L.; Wang, Y.Y.; Huang, J.; Chen, C.Y.; Wang, Z.X.; Xie, H. Silver nanoparticles: Synthesis, medical applications and biosafety. Theranostics 2020, 10, 8996–9031. [Google Scholar] [CrossRef]

| Membrane | Surface Elemental Composition (at%) | ||||
|---|---|---|---|---|---|
| C | N | O | Cl | Ag | |
| TFC | 70.19 | 14.48 | 14.44 | 0.88 | 0 |
| Cl-TFN | 69.89 | 12.84 | 16.38 | 0.89 | 0 |
| TFN-Ag 4 | 62.53 | 14.22 | 15.07 | 1.56 | 6.9 |
Disclaimer/Publisher’s Note: The statements, opinions and data contained in all publications are solely those of the individual author(s) and contributor(s) and not of MDPI and/or the editor(s). MDPI and/or the editor(s) disclaim responsibility for any injury to people or property resulting from any ideas, methods, instructions or products referred to in the content. |
© 2023 by the authors. Licensee MDPI, Basel, Switzerland. This article is an open access article distributed under the terms and conditions of the Creative Commons Attribution (CC BY) license (https://creativecommons.org/licenses/by/4.0/).
Share and Cite
Mi, Y.-F.; Liu, J.-L.; Xia, W.; He, S.-H.; Shentu, B.-Q. In Situ Formation of Silver Nanoparticles Induced by Cl-Doped Carbon Quantum Dots for Enhanced Separation and Antibacterial Performance of Nanofiltration Membrane. Membranes 2023, 13, 693. https://doi.org/10.3390/membranes13080693
Mi Y-F, Liu J-L, Xia W, He S-H, Shentu B-Q. In Situ Formation of Silver Nanoparticles Induced by Cl-Doped Carbon Quantum Dots for Enhanced Separation and Antibacterial Performance of Nanofiltration Membrane. Membranes. 2023; 13(8):693. https://doi.org/10.3390/membranes13080693
Chicago/Turabian StyleMi, Yi-Fang, Jia-Li Liu, Wen Xia, Shu-Heng He, and Bao-Qing Shentu. 2023. "In Situ Formation of Silver Nanoparticles Induced by Cl-Doped Carbon Quantum Dots for Enhanced Separation and Antibacterial Performance of Nanofiltration Membrane" Membranes 13, no. 8: 693. https://doi.org/10.3390/membranes13080693
APA StyleMi, Y.-F., Liu, J.-L., Xia, W., He, S.-H., & Shentu, B.-Q. (2023). In Situ Formation of Silver Nanoparticles Induced by Cl-Doped Carbon Quantum Dots for Enhanced Separation and Antibacterial Performance of Nanofiltration Membrane. Membranes, 13(8), 693. https://doi.org/10.3390/membranes13080693
